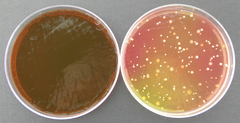
Firmicutes
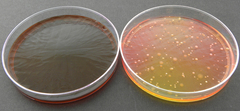
Firmicutes

Firmicutes: taxon details and analytics
- Domain
- Kingdom
- Bacteria
- Phylum
- Firmicutes
- Class
- Order
- Family
- Genus
- Species
- Scientific Name
- Firmicutes
Summary description from Wikipedia:
Firmicutes
The Bacillota (synonym "Firmicutes") are a phylum of bacteria, most of which have Gram-positive cell wall structure. They have round cells, called cocci (singular coccus), or rod-like forms (bacillus). A few Bacillota, such as Megasphaera, Pectinatus, Selenomonas, and Zymophilus from the class Negativicutes, have a porous pseudo-outer membrane that causes them to stain Gram-negative. Many Bacillota produce endospores, which are resistant to desiccation and can survive extreme conditions. They are found in various environments, and the group includes some notable pathogens. Those in one family, the Heliobacteria, produce energy through anoxygenic photosynthesis. Bacillota play an important role in beer, wine, and cider spoilage.
...Firmicutes in languages:
- Chinese
- 厚壁菌門
- English
- firmicutes
Parent Taxon
Sibling Taxa
- Acidobacteria
- Actinobacteria
- Aquificae
- Armatimonadetes
- Bacteroidetes
- Caldiserica
- Chlamydiae
- Chlorobi
- Chloroflexi
- Chrysiogenetes
- Cyanobacteria
- Deferribacteres
- Deinococcus-thermus
- Dictyoglomi
- Elusimicrobia
- Fibrobacteres
- Firmicutes
- Fusobacteria
- Gemmatimonadetes
- Lentisphaerae
- Nitrospira
- Planctomycetes
- Proteobacteria
- Spirochaetae
- Synergistetes
- Tenericutes
- Thermodesulfobacteria
- Thermotogae
- Verrucomicrobia